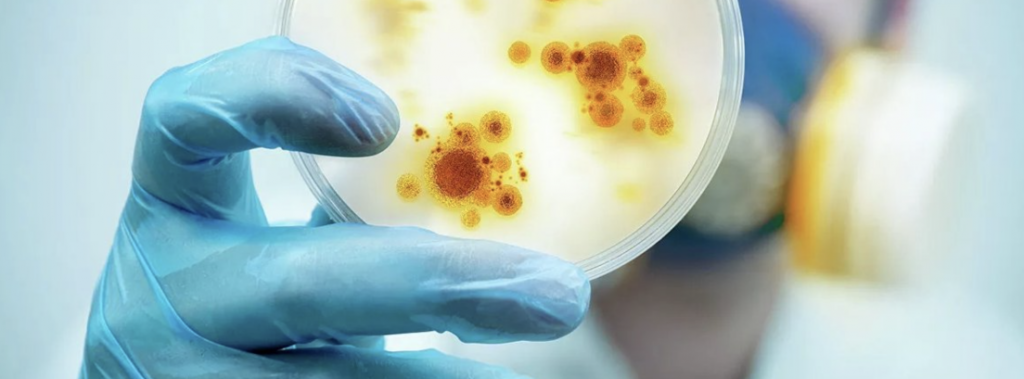

Протоколы ЭКО
Существует несколько протоколов (программ) ЭКО, различающихся длительностью, наличием дополнительных мер и условиями применения. В настоящее время используются следующие из них:
- Естественный (ЭКО в естественном цикле) – не включает прием гормональных стимуляторов яичников, яйцеклетка образуется в результате обычной овуляции;
- Короткий – в этом протоколе стимуляция яичников осуществляется с началом менструации, что сокращает время процедуры, но не позволяет управлять ростом фолликулов;
- Суперкороткий (Токийский) – заключается в минимальной стимуляции яичников для предотвращения осложнений, вызываемых гормональным дисбалансом, используется также при криоконсервации эмбрионов;
- Длинный – назначается до менструации и включает этапы управления работой гипофиза и яичников, стимуляции роста фолликулов и овуляции;
- Длинный с мягкой стимуляцией – включает несколько этапов стимуляции-торможения яичников для максимального созревания небольших яйцеклеток;
- Криопротокол – в нем для экстракорпорального оплодотворения используются замороженные половые клетки или эмбрионы.
Стандартный протокол ЭКО включает этап стимулирования яичников гормональными препаратами с целью вызвать образование нескольких фолликулов (и, соответственно, яйцеклеток) за один менструальный цикл. Это позволяет получить большее число эмбрионов, что увеличивает шанс на успешное наступление беременности.
Как проводится диагностическая гистероскопия
Метод не предполагает выполнения разрезов, накладывания швов, наличия кровотечения, поэтому его относят к категории малоинвазивных
Однако при проведении процедуры важно, чтобы пациентка лежала неподвижно, не чувствовала боли, дискомфорта, поэтому врачи используют местную анестезию, а в некоторых случаях – общий наркоз.. Гистероскопия проходит в несколько этапов:
Гистероскопия проходит в несколько этапов:
- Через влагалище и шейку матки врач вводит трубку аппарата с камерой.
- Картинка в режиме онлайн передается на экран. Это позволяет гинекологу оценить состояние полости матки, изучить структуру эндометрия. Также врач установит толщину слизистого слоя, проконтролирует его состояние, в том числе обнаружит врожденные аномалии, полипы, новообразования, спайки.
- Если доктору необходимо получить данные для дальнейшего исследования (биопсия тканей) или провести лечебные манипуляции, в матку через установленную трубку дополнительно вводят манипуляторы – хирургические инструменты.
Процедуру проводят только натощак. Предварительно выполняют очистительную клизму для опорожнения кишечника, также женщине нужно опорожнить мочевой пузырь.
Гистероскопию проводят на гинекологическом кресле.
Обратите внимание, что необходимо соблюдать рекомендации после манипуляции. В течение 3–4 недель следует:
Исключить подъем тяжестей, высокие физические нагрузки.
Отказаться от близости с партнером.
Избегать бань, бассейнов, саун.
Уделить особое внимание интимной гигиене (в частности, врачи рекомендуют отказаться от тампонов и заменить их гигиеническими прокладками).
Как происходит криоперенос эмбрионов?
Зародыши, достигшие стадии балстоцисты, до криопереноса хранятся в криобанке в замороженном состоянии. Технология сверхбыстрой заморозки с использованием криопротекторов позволяет избежать образования микрокристаллов льда и повреждения ими клеток эмбрионов. В таком состоянии биоматериал может храниться неограниченно долго. Сам криоперенос выполняется в несколько этапов:
- Разморозка эмбрионов. Зародыши размораживаются при комнатной температуре в стерильных условиях. Из них врач-эмбриолог отбраковывает те, в строении которых наблюдаются негативные изменения. У отобранных эмбрионов специально повреждается защитная «блестящая» оболочка (zona pellucida) – это позволяет ускорить их имплантацию в эндометрий матки.
- Перенос эмбрионов. Сама процедура эмбриотрансфера проходит в гинекологическом кабинете, обычно без наркоза или местного обезболивания, под контролем УЗИ. С помощью расширителей и зеркал врач обнажает шейку матки и очищает ее от цервикального секрета, после чего вводит через нее в маточную полость гибкий катетер, соединенный со шприцом – из него он выдавливает жидкость с содержащимися в ней эмбрионами.
- Гормональная поддержка. После переноса пациентка в течение 1,5-2 часов отдыхает в палате, после чего может отправляться домой. Никаких строгих требований соблюдать не нужно, за исключением случаев, когда у женщины имеются какие-либо заболевания. Для успешной имплантации эмбрионов, как правило, назначается курс прогестерона, который создает в матке наиболее благоприятные условия для развития плода. Продолжительность гормонального курса и дозировку препарата врач определяет индивидуально для каждой пациентки, основываясь на данных обследований и ее медицинской карты.
Сделайте первый шагзапишитесь на прием к врачу!
Записаться на прием к врачу
В зависимости от возраста, состояния здоровья пациентки и других факторов криоперенос эмбрионов после неудачного ЭКО может включать и дополнительные процедуры. Врач подбирает подходящую программу, позволяющую максимально увеличить шансы на у4спешное наступление беременности.
Преимущества и недостатки криопереноса
Широкому распространению этой репродуктивной технологии способствуют следующие преимущества:
- Повышенная вероятность наступления беременности, достигающая 50%, в то время как стандартный протокол ЭКО эффективен в 30-35% случаев;
- Возможность забеременеть после угасания функции яичников за счет имплантации эмбрионов, полученных ранее и сохраненных в криобанке;
- Уменьшение числа стимуляций суперовуляций и, как следствие, снижение риска возникновения синдрома гиперстимуляции яичников, уменьшение общей стоимости процедуры ЭКО;
- Возможность выбрать наиболее подходящий момент для имплантации, что позволяет лучше подготовить матку к переносу и, тем самым, увеличить шансы на наступление беременности;
- Снижение риска осложнений за счет тщательного отбора эмбрионов и подготовки организма женщины к беременности.
К недостаткам крипротокола после ЭКО можно отнести только ограниченное количество замороженных эмбрионов. В большинстве случаев его достаточно для проведения хотя бы одной успешной пересадки, но, если родители желает иметь еще детей в будущем, им необходимо позаботиться заранее о запасе необходимого числа эмбрионов. Кроме того, хранение биоматериала в криобанке – платная услуга, что вызывает определенные расходы.
Показания к проведению лапароскопии перед экстракорпоральным оплодотворением
По утверждению специалистов лапароскопия перед ЭКО необходима в обязательном порядке. Это малоинвазивное вмешательство позволяет установить причины бесплодия и устранить их, а также создать наиболее подходящие для зачатия условия. Тем не менее, большинство женщин, которым предстоит эта процедура, сомневаются, обязательно ли делать лапароскопию.
Чтобы избавиться от сомнений относительно целесообразности проведения операции, важно помнить, что выбор — лапароскопия или ЭКО — не стоит перед врачами, так как последнее в большинстве случаев невозможно без первого. Такая связь объясняется тем, что лапароскопию назначают только при явных проблемах с репродуктивными органами, которые можно устранить только в ходе оперативного вмешательства
В каких случаях показана малоинвазивная операция:
- Спаечный процесс в области матки и придатков — связки, удерживающие репродуктивные органы, срастаются, из-за чего матка принимает нетипичное положение при развитии беременности. Этот процесс в большинстве случаев приводит к невынашиванию плода. Если в процесс вовлечены маточные трубы, оплодотворение становится вовсе невозможным, а также существует риск внематочной беременности. Поэтому ЭКО при непроходимости труб проводится только после восстановления просвета яйцевода в ходе лапароскопии.
- Эндометриоз, при котором очаги могут располагаться в полости матки, на ее наружной поверхности и на яичниках, в цервикальном канале. Заболевание в большинстве случаев приводит к гормональной неустойчивости, которая препятствует наступлению и развитию беременности. Лапароскопия — лучший метод для удаления эндометриоидных очагов без значительного травмирования репродуктивных органов.
- Воспаление придатков, при которых состояние маточных труб может быть неподходящим для прохождения по ним оплодотворенной яйцеклетки. Проведение малоинвазивного вмешательства с использованием лапароскопа позволяет восстановить функции органов и уменьшить риск развития внематочной беременности.
- Новообразования в репродуктивной системе. Посредством лапароскопии проводят удаление кисты яичника, миом, других доброкачественных опухолей, которые мешают зачатию или правильному развитию беременности.
В случае если подготовка и ход операции прошли без сбоев, врач проявил необходимую компетенцию, а женщина соблюдала рекомендации в послеоперационный период, функции репродуктивной системы после лапароскопии восстанавливаются.
Полезно знать! Примерно 20% женщин, прошедших через процедуру лапароскопии перед искусственным оплодотворением, беременеют самостоятельно до того, как будет проведено ЭКО.

Самостоятельный прием лекарств
В большинстве случаев женщины решают делать инъекции самостоятельно. Препараты вкалываются внутримышечно или подкожно. Самым простым способом является использование специального устройства — ручки-инжектора.

Отклонение от рекомендаций по приему лекарств может привести к осложнениям
Важно соблюдать указанную дозировку и ставить уколы строго через определенные промежутки времени. При введении лекарства необходимо помнить о том, что:
- средства вводятся очень медленно;
- при пропуске времени инъекции необходимо сразу же сообщить врачу, время приема лекарства в этом случае должно быть согласовано с репродуктологом;
- нужно следить за дозировкой и не изменять ее;
- перед уколом обязательно продезинфицируйте руки и место инъекции.
Инфекции и беременность: возможные риски
Беременность с помощью ЭКО кардинально ничем не отличается от естественной, за исключением механизма оплодотворения – он происходит вне организма женщины в специальном инкубаторе. Оплодотворенная яйцеклетка затем пересаживается в матку пациентки, после чего она вынашивает и рожает ребенка обычным путем. Соответственно, беременность после экстракорпорального оплодотворения подвержена тем же рискам, одним из которых является заражение плода материнскими инфекциями. Воздействие инфекционных возбудителей на ребенка во внутриутробный период достаточно разнообразно и зависит от многих факторов, среди которых состояние организма самого эмбриона, тип заболевания, срок инфицирования и т. д. К наиболее распространенным негативным последствиям заражения инфекцией матери и ее плода при ЭКО относятся:
- самопроизвольное прерывание беременности (выкидыш) – обычно развивается на раннем (первые 2 недели) сроке инфицирования из-за нарушения процесса образования эмбриона;
- замершая беременность – аномалия, возникающая обычно в первом триместре беременности и выражающаяся в прекращении развития плода, его смерти и последующем выкидыше;
- пороки развития – аномалии тканей и органов плода, возникающие из-за непосредственного воздействия на них инфекционного агента (бактерии, вируса, грибка и т. д.) или вследствие иммунной реакции на них со стороны организма самого ребенка или его матери;
- заболевания в более позднем возрасте – в этом случае зараженный ребенок рождается здоровым, но инфекция или ее побочные эффекты проявляются в нем в более позднем возрасте.
Тяжесть последствий заражения в период внутриутробного развития индивидуальна и может варьироваться от тяжелых поражений, несовместимых с жизнью, до тяжелых, средних и легких отклонений. Часто зараженные дети не заболевают сами, но являются носителями инфекций и могут передать их своим детям или другим людям. Возможна и полная санация инфекционного возбудителя организмом ребенка с выработкой иммунитета
Точно предугадать течение таких инфекций невозможно, поэтому рекомендуется их профилактика (вакцинация, соблюдение мер предосторожности) или оперативное лечение до или в период беременности.
Попадание инфекционного возбудителя в организм ребенка в период вынашивания после естественного зачатия или ЭКО возможно следующими путями:
- трансплацентарным – из кровотока матери в кровеносную систему плода через плаценту (характерно для токсоплазмоза и вирусных заболеваний);
- восходящим – при попадании инфекции (например, хламидий, грибков, бактерий) из влагалища женщины в ее матку с последующим инфицированием плода;
- нисходящим – при проникновении инфекционных возбудителей из маточных труб в полость матки;
- контактным – при прохождении плода во время родов по зараженным половым путям матери.
Также ребенок может заразиться во время родов при контакте с зараженной кровью или выделениями (мочой, калом) матери или при совершении хирургических манипуляций плохо простерилизованными инструментами.
О необходимости стимуляции
Перед процедурой ЭКО женский организм стимулируют средствами, обеспечивающими созревание одновременно нескольких яйцеклеток. Стимуляция перед процедурой необходима, чтобы иметь возможность получить возможно большее их число. Для этого делаются специальные уколы в течение двух недель – ежедневно.
Стимуляция при ЭКО не является лечением. Эти действия ставят целью извлечь максимально возможное количество фолликулов, чтобы обеспечить хорошее поле деятельности и получить положительный результат. На этой стадии успех определяет квалификация и опыт врачей.
Единственное, что требуется от будущей мамочки – соблюдать все предписания врача, когда проходит стимуляция во время ЭКО.
Полностью созревшие фолликулы изымаются. Пункция фолликулов при ЭКО – не болезненная, малотравматичная процедура, предусматривает получение максимально возможного количества фолликулов.
Проведение ЭКО после пункции предваряет курс диферелина, чтобы предупредить развитие синдрома гиперстимуляции. Инъекции могут вызвать небольшую болезненность внизу живота, что считается нормальной реакцией.
Обязательный препарат для успешного приживления эмбрионов – пироксикам. Примерно за час до процедуры пациентка принимает таблетку, чтобы возможность успешного внедрения в матку была максимальной. Препарат стимулирует активный приток крови к малому тазу, это также положительное явление для прикрепления эмбриона к матке.
Нужно ли лежать в постели две недели после переноса эмбриона? Можно ли двигаться? Когда можно вставать?
Самое главное, что нужно сделать после переноса эмбрионов — это расслабиться. Прежде всего, необходимо после переноса эмбрионов создать для мамы состояние психологической поддержки, чтобы избежать излишних переживаний по поводу возможных проблем с имплантацией эмбрионов.
Нужно понять, что обычное поведение женщины после переноса эмбрионов, если оно не является экстремальным (тяжелые физические нагрузки, прыжки с парашютом, ныряние с аквалангом и проч.), не отражается на эффективности протокола ЭКО. Эмбрион не выпадет из матки, если вы встанете с постели. Он не выкатится, если вы присядете или пройдетесь пешком.
Нет необходимости замирать в постели после переноса эмбрионов. Обычно рекомендуют полежать после переноса в течение 30 минут, но это необходимо прежде всего для того, чтобы женщина успокоилась, чтобы тонус матки уменьшился, а совсем не для того, чтобы эмбрион прикрепился.
Его прикрепление наступает в течение 24-40 часов после переноса, и оно мало зависит от того, лежит человек все эти 40 минут на кровати, либо ведет обычный образ жизни, лишь исключив ряд стрессовых факторов. Более того, есть исследования, которые доказывают: отсутствие активности женщины после переноса уменьшает кровоток в полости матки, что неблагоприятно сказывается на вероятности наступления беременности, и процент эффективных программ в этом случае ниже, чем у тех, кто сразу после переноса продолжил активную деятельность.
Но есть ряд моментов, которые повышают шансы на имплантацию. После переноса эмбрионов нужно начать относиться к себе как к беременной женщине.
Минимизируйте стрессовые факторы: старайтесь не нервничать, хорошо отдохните после переноса, выполняйте все рекомендации врача — особенно важно контролировать уровень гормонов и вовремя корректировать терапию. Если беспокоит страх — принимайте успокаивающие (валериана, глицин)
Не нужно бегать каждые два дня в туалет с тестом на беременность, все это лишняя эмоциональная нагрузка: уровень ХГЧ может быть еще недостаточно высок, чтобы отразится в результатах анализа мочи, а вот стресс от того, что тест на беременность отрицательный при исследовании раньше времени, приводит к повышению тонуса матки и неблагоприятно сказывается на течении беременности.
Важные ограничения, которые призваны помочь удержать эмбрионы в полости матки:
- избегать горячих водных процедур (ванна, баня, сауна). Душ — можно!
- избегать подъема тяжестей;
- исключить спортивные упражнения, связанные с интенсивной физической нагрузкой. Нежелателен велосипед. Бег, фитнес, плавание — не противопоказаны;
- избегать затруднений со стулом. Рекомендуется есть побольше фруктов и овощей, особенно чернослив, свеклу;
- исключить алкоголь и курение.
Какова эффективность ЭКО?
Пациенты, впервые проходящие процедуру экстракорпорального оплодотворения, часто ожидают положительного результата уже на первой попытке. В реальности эффективность ЭКО не превышает шансов на естественную беременность у здоровых людей и составляет примерно 35%. Вероятность забеременеть искусственным путем зависит от многих факторов:
- возраста и состояния здоровья пациента;
- квалификации врача, выполняющего процедуру;
- использования дополнительных репродуктивных технологий;
- количества подсаженных эмбрионов и т. д.
Если с первой попытки забеременеть не удалось, врач проводит дополнительные обследования пациентов, чтобы выяснить, почему ЭКО не получилось с первого раза. Именно для этого предварительно женщина проходит этап гормональной стимуляции, позволяющий за 1 менструальный цикл получить большее количество фертильных яйцеклеток.
Сделайте первый шагзапишитесь на прием к врачу!
Записаться на прием к врачу
Протоколы стимуляции
В зависимости от здоровья женщины и причин бесплодия используют различные схемы ССО. Они отличаются сроками и дозировками препаратов. Наиболее популярны два протокола:
- длинный протокол ЭКО. Стимуляцию начинают на 19–22 день менструального цикла. Для начала максимально подавляют выработку гормона ЛГ, а затем уже стимулируют рост фолликулов;
- короткий протокол ЭКО. ССО начинается на 4–5 день менструального цикла и длится около 10 дней. Важным отличием является использование малых дозировок, что помогает пациенткам легче переносить процедуру.
Помимо этого существуют ультрадлинный и ультракороткий протокол, а также естественный цикл.
Любая стимуляция проводится под строгим контролем за развитием фолликулов и уровнем гормонов. В соответствии с результатами УЗИ репродуктолог может пересмотреть протокол и повысить либо понизить дозировку, перейти на другой протокол.
Успех процедуры зависит от количества доминантных фолликулов
Главная задача — получение зрелых яйцеклеток. Чем больше фолликулов сформируется, тем выше вероятность добиться положительного результата. Существует мнение, что длинный протокол дает больше шансов забеременеть. Но это в значительной степени связано с первоначальным состоянием пациенток, так как по длинной схеме работают с женщинами с хорошим фолликулярным резервом.
Что делать после ЭКО
Неважно, сколько яйцеклеток подсаживают при ЭКО. Женщина должна выполнять ряд правил, чтобы в ближайшем будущем стать мамой:
- в первые 10 дней полностью исключить все физические нагрузки. Постельный режим вводить не стоит, но резкие движения и занятия спортом противопоказаны;
- не следует вступать в половой контакт первые 3 месяца;
- каждый день измерять базальную температуру, причем делать это нужно в одно и то же время. Если на протяжении 3–5 дней она держится ниже уровня 37 градусов, следует идти к врачу;
- в рационе должно присутствовать большое количество овощей, фруктов, белковой пищи. Лучше, если блюда будут приготовлены на пару.
Видео: Интересная информация об эмбриологии
Врач акушер-гинеколог, врач-репродуктолог, врач ультразвуковой диагностики. Главный врач клиники. / Член Российской и Европейской Ассоциация Репродукции Человека
В заключение
Экстракорпоральное оплодотворение, являясь эффективным методом борьбы с бесплодием, требует от обоих родителей максимальной ответственности. Перед процедурой семейные пары и одинокие женщины проходят предварительную консультацию с врачом, который информирует их о шансах на наступление беременности, возможных осложнениях, дает соответствующие рекомендации по подготовке к процедуре. Этот этап необходим в том числе по психологическим причинам – он дает будущим родителям возможность объективно оценить свою готовность к ЭКО.
Важное значение имеет также вопрос – где лучше делать ЭКО? Из-за высокой сложности этой технологии, а также строгого государственного регулирования в данной области такие услуги предоставляют только крупные медицинские центры, имеющие соответствующую лицензию. Однако, они различаются по уровню оснащения, подготовки персонала и другим параметрам, поэтому выбирать клинику для ЭКО необходимо тщательно
В медицинском центре «За Рождение» есть все необходимое для того, чтобы шансы на успешное наступление беременности были максимально высокими, а сама она протекла без осложнений. Чтобы узнать подробнее о наших услугах, звоните по телефону +7 (800) 222-40-58.




































